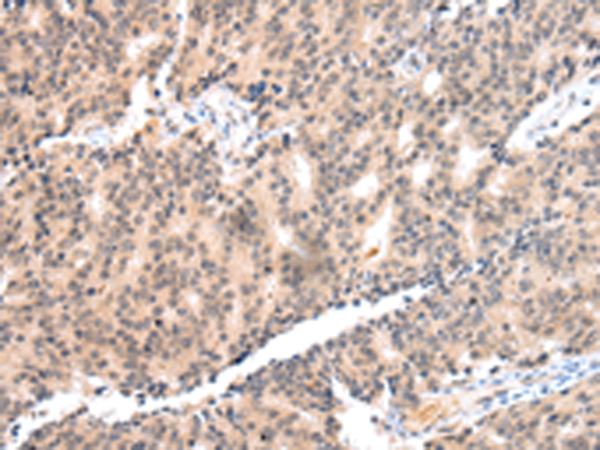

中文名稱: 兔抗COX17多克隆抗體
|
Background: |
Cytochrome c oxidase (COX), the terminal component of the mitochondrial respiratory chain, catalyzes the electron transfer from reduced cytochrome c to oxygen. This component is a heteromeric complex consisting of 3 catalytic subunits encoded by mitochondrial genes and multiple structural subunits encoded by nuclear genes. The mitochondrially-encoded subunits function in electron transfer, and the nuclear-encoded subunits may function in the regulation and assembly of the complex. This nuclear gene encodes a protein which is not a structural subunit, but may be involved in the recruitment of copper to mitochondria for incorporation into the COX apoenzyme. This protein shares 92% amino acid sequence identity with mouse and rat Cox17 proteins. This gene is no longer considered to be a candidate gene for COX deficiency. A pseudogene COX17P has been found on chromosome 13. |
|
Applications: |
ELISA, IHC |
|
Name of antibody: |
COX17 |
|
Immunogen: |
Synthetic peptide of human COX17 |
|
Full name: |
COX17 cytochrome c oxidase copper chaperone |
|
SwissProt: |
Q14061 |
|
ELISA Recommended dilution: |
2000-10000 |
|
IHC positive control: |
Human prostate cancer |
|
IHC Recommend dilution: |
40-250 |
購物車
幫助
021-54845833/15800441009
